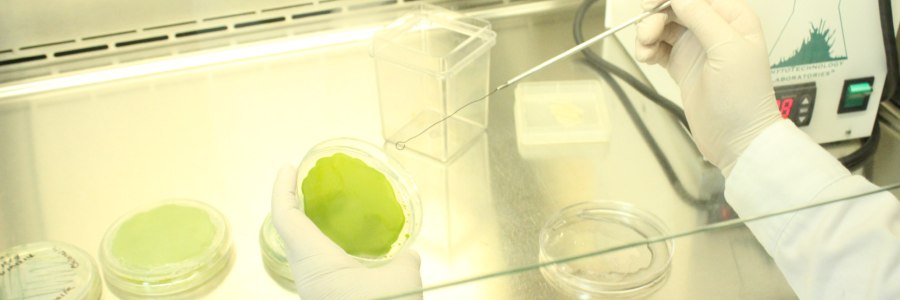

Necesario impulsar la cultura de la protección intelectual: CICY
-El CICY cuenta con 30 patentes y 23 solicitudes en proceso Mérida, Yucatán, 25 de abril de 2022.- Es prioritario impulsar la cultura de la protección de la propiedad intelectual para dar paso al surgimiento de nuevas tecnologías e invenciones que favorezcan el desarrollo científico, económico y de bienestar para las comunidades y la sociedad,… Leer más Necesario impulsar la cultura de la protección intelectual: CICY